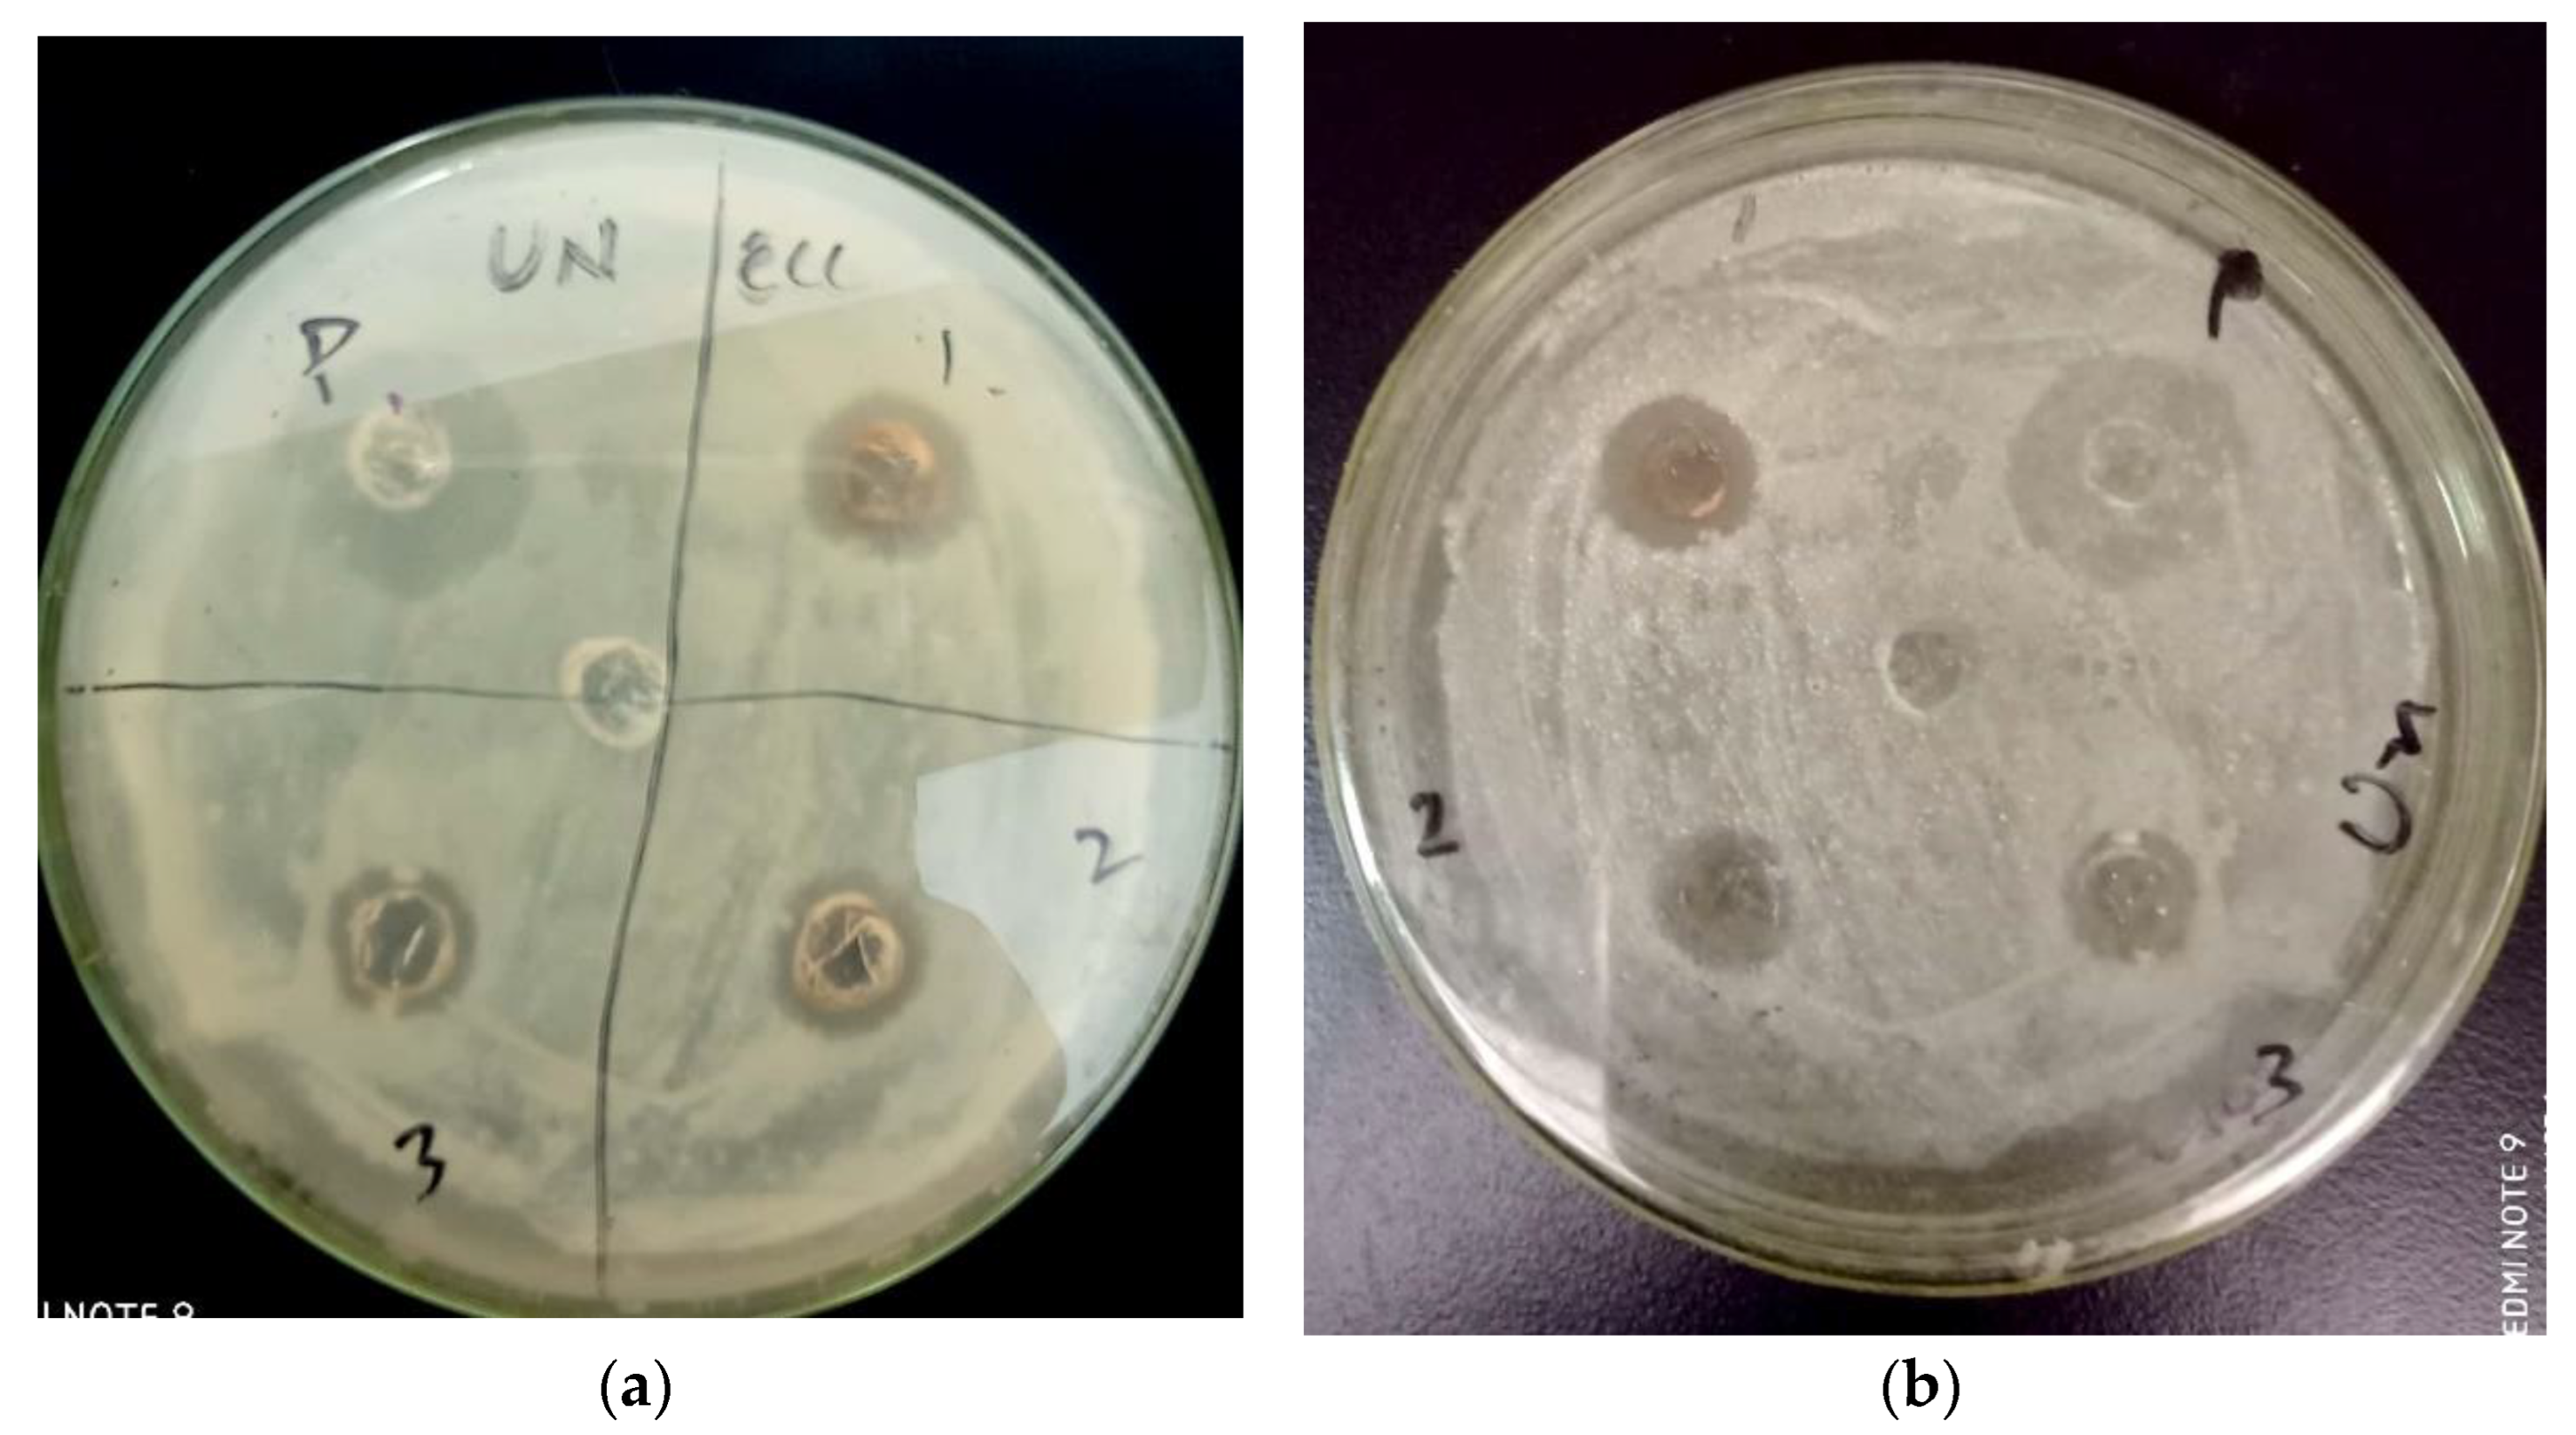
Inorganics 11 00309 g008

Biologically Synthesized Silver Nanoparticles Efficiently Control Plant Pathogenic Bacteria-Erwinia carotovora and Ralstonia solanacearum
Abstract
1. Introduction
2. Results
2.1. Visual Observation of the Synthesized AgNPs
2.2. Characterization of AgNPs by UV-Vis Spectroscopy
2.3. Physical Characterization
2.3.1. Fourier Transform Infrared Spectroscopy
2.3.2. Transmission Electron Microscopy Analysis
2.3.3. EDX Analysis
2.4. In Vitro Antimicrobial Analysis
2.4.1. Growth Inhibition of Erwinia carotovora subsp. atroseptica (ECA)
2.4.2. Growth Inhibition of Erwinia carotovora subsp. carotovora (ECC)
2.4.3. Growth Inhibition of Ralstonia solanacearum
2.4.4. Well Diffusion Assay
2.5. Potato Tubers Infectivity Assay
2.6. Prevention of Bacterial Wilt Disease in Tomato Plants
3. Discussion
4. Materials and Methods
4.1. Collection and Processing of Plants
4.2. Preparation of Plant Aqueous Extract and Silver Nitrate Solutions
4.3. Biosynthesis of Silver Nanoparticles (AgNPs)
4.4. UV-Visible Spectroscopy
4.5. Physical Characterization
4.6. Antibacterial Assays
4.6.1. Microtiter Plate Reader Assay
4.6.2. Well Diffusion Assay
4.7. In Planta Phytopathogens Inhibition Assay
4.7.1. Potato Tubers Assay
4.7.2. Soil-Drenching Experiment for Bacterial Wilt Disease
5. Conclusions
Author Contributions
Funding
Data Availability Statement
Conflicts of Interest
References
- Shuping, D.; Eloff, J.N. The use of plants to protect plants and food against fungal pathogens: A review. Afr. J. Tradit. Complement. Altern. Med. 2017, 14, 120–127. [Google Scholar] [CrossRef]
- Pandey, S.; Giri, K.; Kumar, R.; Mishra, G.; Raja Rishi, R. Nanopesticides: Opportunities in crop protection and associated environmental risks. Proc. Natl. Acad. Sci. India Sect. B Biol. Sci. 2018, 88, 1287–1308. [Google Scholar] [CrossRef]
- Nassar, A.M.K. Pesticide alternatives use in Egypt: The concept and potential. In Sustainability of Agricultural Environment in Egypt: Part II: Soil-Water-Plant Nexus; Springer: Cham, Switzerland, 2019; pp. 111–143. [Google Scholar]
- Hossain, L.; Rahman, R.; Khan, M.S. Alternatives of pesticides. In Pesticide Residue in Foods: Sources, Management, and Control; Springer: Cham, Switzerland, 2017; pp. 147–165. [Google Scholar]
- Pathak, V.M.; Verma, V.K.; Rawat, B.S.; Kaur, B.; Babu, N.; Sharma, A.; Dewali, S.; Yadav, M.; Kumari, R.; Singh, S. Current status of pesticide effects on environment, human health and it’s eco-friendly management as bioremediation: A comprehensive review. Front. Microbiol. 2022, 13, 2833. [Google Scholar] [CrossRef]
- Fakruddin, M.; Hossain, Z.; Afroz, H. Prospects and applications of nanobiotechnology: A medical perspective. J. Nanobiotechnology 2012, 10, 31. [Google Scholar] [CrossRef]
- Ditta, A.; Arshad, M.; Ibrahim, M. Nanoparticles in sustainable agricultural crop production: Applications and perspectives. In Nanotechnology and Plant Sciences: Nanoparticles and Their Impact on Plants; Springer: Cham, Switzerland, 2015; pp. 55–75. [Google Scholar]
- Syed, B.; Prasad, M.N.; Satish, S. Synthesis and characterization of silver nanobactericides produced by Aneurinibacillus migulanus 141, a novel endophyte inhabiting Mimosa pudica L. Arab. J. Chem. 2019, 12, 3743–3752. [Google Scholar] [CrossRef]
- Servin, A.; Elmer, W.; Mukherjee, A.; De la Torre-Roche, R.; Hamdi, H.; White, J.C.; Bindraban, P.; Dimkpa, C. A review of the use of engineered nanomaterials to suppress plant disease and enhance crop yield. J. Nanopart. Res. 2015, 17, 92. [Google Scholar] [CrossRef]
- Durán, N.; Marcato, P.D. Nanobiotechnology perspectives. Role of nanotechnology in the food industry: A review. Int. J. Food Sci. Technol. 2013, 48, 1127–1134. [Google Scholar] [CrossRef]
- Gogos, A.; Knauer, K.; Bucheli, T.D. Nanomaterials in plant protection and fertilization: Current state, foreseen applications, and research priorities. J. Agric. Food Chem. 2012, 60, 9781–9792. [Google Scholar] [CrossRef]
- Perlatti, B.; de Souza Bergo, P.L.; Fernandes, J.B.; Forim, M.R. Polymeric nanoparticle-based insecticides: A controlled release purpose for agrochemicals. In Insecticides-Development of Safer and More Effective Technologies; IntechOpen: London, UK, 2013. [Google Scholar]
- Al-Samarrai, A. Nanoparticles as alternative to pesticides in management plant diseases—A review. Int. J. Sci. Res. Publ. 2012, 2, 1–4. [Google Scholar]
- Raveendran, P.; Fu, J.; Wallen, S.L. Completely “green” synthesis and stabilization of metal nanoparticles. J. Am. Chem. Soc. 2003, 125, 13940–13941. [Google Scholar] [CrossRef]
- Thorley, A.J.; Tetley, T.D. New perspectives in nanomedicine. Pharmacol. Ther. 2013, 140, 176–185. [Google Scholar] [CrossRef]
- Kim, S.W.; Jung, J.H.; Lamsal, K.; Kim, Y.S.; Min, J.S.; Lee, Y.S. Antifungal effects of silver nanoparticles (AgNPs) against various plant pathogenic fungi. Mycobiology 2012, 40, 53–58. [Google Scholar] [CrossRef]
- Kaur, G.; Verma, R.; Rai, D.; Rai, S. Plasmon-enhanced luminescence of Sm complex using silver nanoparticles in polyvinyl alcohol. J. Lumin. 2012, 132, 1683–1687. [Google Scholar] [CrossRef]
- Arif, M.; Ullah, R.; Ahmad, M.; Ali, A.; Ullah, Z.; Ali, M.; Al-Joufi, F.A.; Zahoor, M.; Sher, H. Green synthesis of silver nanoparticles using Euphorbia wallichii leaf extract: Its antibacterial action against citrus canker causal agent and antioxidant potential. Molecules 2022, 27, 3525. [Google Scholar] [CrossRef]
- Alam, T.; Khan, R.A.A.; Ali, A.; Sher, H.; Ullah, Z.; Ali, M. Biogenic synthesis of iron oxide nanoparticles via Skimmia laureola and their antibacterial efficacy against bacterial wilt pathogen Ralstonia solanacearum. Mater. Sci. Eng. C 2019, 98, 101–108. [Google Scholar] [CrossRef]
- Gudkov, S.V.; Serov, D.A.; Astashev, M.E.; Semenova, A.A.; Lisitsyn, A.B. Ag2O nanoparticles as a candidate for antimicrobial compounds of the new generation. Pharmaceuticals 2022, 15, 968. [Google Scholar] [CrossRef]
- Shen, W.; Li, P.; Feng, H.; Ge, Y.; Liu, Z.; Feng, L. The bactericidal mechanism of action against Staphylococcus aureus for AgO nanoparticles. Mater. Sci. Eng. C 2017, 75, 610–619. [Google Scholar] [CrossRef]
- Kim, J.S.; Kuk, E.; Yu, K.N.; Kim, J.-H.; Park, S.J.; Lee, H.J.; Kim, S.H.; Park, Y.K.; Park, Y.H.; Hwang, C.-Y. Antimicrobial effects of silver nanoparticles. Nanomed. Nanotechnol. Biol. Med. 2007, 3, 95–101. [Google Scholar] [CrossRef]
- Chen, X.; Schluesener, H.J. Nanosilver: A nanoproduct in medical application. Toxicol. Lett. 2008, 176, 1–12. [Google Scholar] [CrossRef]
- Ali, M.; Kim, B.; Belfield, K.D.; Norman, D.; Brennan, M.; Ali, G.S. Inhibition of Phytophthora parasitica and P. capsici by silver nanoparticles synthesized using aqueous extract of Artemisia absinthium. Phytopathology 2015, 105, 1183–1190. [Google Scholar] [CrossRef]
- Stephenson, G.R.; Coats, J.; Yamamoto, H. Pesticide use and world food production: Risks and benefits. In Proceedings of the Expert Committee on Weeds Comité D’experts en Malherbologie, Proceedings of the 2000 National Meeting, Banff, AB, Canada, 26–30 November 2001; pp. 9–15.
- Li, Y.; Zhang, P.; Li, M.; Shakoor, N.; Adeel, M.; Zhou, P.; Guo, M.; Jiang, Y.; Zhao, W.; Lou, B. Application and mechanisms of metal-based nanoparticles in the control of bacterial and fungal crop diseases. Pest Manag. Sci. 2023, 79, 21–36. [Google Scholar] [CrossRef]
- Yadav, S.A.; Suvathika, G.; Alghuthaymi, M.A.; Abd-Elsalam, K.A. Fungal-derived nanoparticles for the control of plant pathogens and pests. In Fungal Cell Factories for Sustainable Nanomaterials Productions and Agricultural Applications; Elsevier: Amsterdam, The Netherlands, 2023; pp. 755–784. [Google Scholar]
- Vijayaram, S.; Razafindralambo, H.; Sun, Y.-Z.; Vasantharaj, S.; Ghafarifarsani, H.; Hoseinifar, S.H.; Raeeszadeh, M. Applications of Green Synthesized Metal Nanoparticles—A Review. Biol. Trace Elem. Res. 2023, 1–27. [Google Scholar] [CrossRef]
- Ali, M.; Kim, B.; Belfield, K.D.; Norman, D.; Brennan, M.; Ali, G.S. Green synthesis and characterization of silver nanoparticles using Artemisia absinthium aqueous extract—A comprehensive study. Mater. Sci. Eng. C 2016, 58, 359–365. [Google Scholar] [CrossRef]
- Mondal, A.K.; Mondal, S.; Samanta, S.; Mallick, S. Synthesis of ecofriendly silver nanoparticle from plant latex used as an important taxonomic tool for phylogenetic interrelationship advances in bioresearch vol. 2. Synthesis 2011, 31, 33. [Google Scholar]
- Mallikarjuna, K.; Narasimha, G.; Dillip, G.; Praveen, B.; Shreedhar, B.; Lakshmi, C.S.; Reddy, B.; Raju, B.D.P. Green synthesis of silver nanoparticles using Ocimum leaf extract and their characterization. Dig. J. Nanomater. Biostruct. 2011, 6, 181–186. [Google Scholar]
- Awwad, A.M.; Salem, N.M.; Abdeen, A.O. Biosynthesis of silver nanoparticles using Loquat leaf extract and its antibacterial activity. Adv. Mater. Lett. 2013, 4, 338–342. [Google Scholar] [CrossRef]
- Singh, P.; Mijakovic, I. Strong antimicrobial activity of silver nanoparticles obtained by the green synthesis in Viridibacillus sp. extracts. Front. Microbiol. 2022, 13, 820048. [Google Scholar] [CrossRef]
- Singh, J.; Dutta, T.; Kim, K.-H.; Rawat, M.; Samddar, P.; Kumar, P. ‘Green’synthesis of metals and their oxide nanoparticles: Applications for environmental remediation. J. Nanobiotechnol. 2018, 16, 1–24. [Google Scholar] [CrossRef]
- Chugh, D.; Viswamalya, V.; Das, B. Green synthesis of silver nanoparticles with algae and the importance of capping agents in the process. J. Genet. Eng. Biotechnol. 2021, 19, 1–21. [Google Scholar] [CrossRef]
- Elavazhagan, T.; Arunachalam, K.D. Memecylon edule leaf extract mediated green synthesis of silver and gold nanoparticles. Int. J. Nanomed. 2011, 6, 1265–1278. [Google Scholar] [CrossRef]
- Majeed, M.; Hakeem, K.R.; Rehman, R.U. Synergistic effect of plant extract coupled silver nanoparticles in various therapeutic applications-present insights and bottlenecks. Chemosphere 2022, 288, 132527. [Google Scholar] [CrossRef]
- Tippayawat, P.; Phromviyo, N.; Boueroy, P.; Chompoosor, A. Green synthesis of silver nanoparticles in aloe vera plant extract prepared by a hydrothermal method and their synergistic antibacterial activity. PeerJ 2016, 4, e2589. [Google Scholar] [CrossRef]
- Dilbar, S.; Sher, H.; Binjawhar, D.N.; Ali, A.; Ali, I. A novel based synthesis of silver/silver chloride nanoparticles from stachys emodi efficiently controls Erwinia carotovora, the causal agent of blackleg and soft rot of potato. Molecules 2023, 28, 2500. [Google Scholar] [CrossRef]
- Ali, G.S.; Reddy, A. Inhibition of fungal and bacterial plant pathogens by synthetic peptides: In vitro growth inhibition, interaction between peptides and inhibition of disease progression. Mol. Plant-Microbe Interact. 2000, 13, 847–859. [Google Scholar] [CrossRef]

Disclaimer/Publisher’s Note: The statements, opinions and data contained in all publications are solely those of the individual author(s) and contributor(s) and not of MDPI and/or the editor(s). MDPI and/or the editor(s) disclaim responsibility for any injury to people or property resulting from any ideas, methods, instructions or products referred to in the content. |
© 2023 by the authors. Licensee MDPI, Basel, Switzerland. This article is an open access article distributed under the terms and conditions of the Creative Commons Attribution (CC BY) license (https://creativecommons.org/licenses/by/4.0/).
Share and Cite
Bibi, Z.; Ali, M.; Abohashrh, M.; Ahmad, I.; Khan, H.; Ali, M.; Akbar, F.; Ahmad, N.; Iqbal, A.; Ullah, F.; et al. Biologically Synthesized Silver Nanoparticles Efficiently Control Plant Pathogenic Bacteria-Erwinia carotovora and Ralstonia solanacearum. Inorganics 2023, 11, 309. https://doi.org/10.3390/inorganics11070309
Bibi Z, Ali M, Abohashrh M, Ahmad I, Khan H, Ali M, Akbar F, Ahmad N, Iqbal A, Ullah F, et al. Biologically Synthesized Silver Nanoparticles Efficiently Control Plant Pathogenic Bacteria-Erwinia carotovora and Ralstonia solanacearum. Inorganics. 2023; 11(7):309. https://doi.org/10.3390/inorganics11070309
Chicago/Turabian StyleBibi, Zainab, Mohammad Ali, Mohammed Abohashrh, Imtiaz Ahmad, Haji Khan, Murad Ali, Fazal Akbar, Nisar Ahmad, Arshad Iqbal, Farman Ullah, and et al. 2023. "Biologically Synthesized Silver Nanoparticles Efficiently Control Plant Pathogenic Bacteria-Erwinia carotovora and Ralstonia solanacearum" Inorganics 11, no. 7: 309. https://doi.org/10.3390/inorganics11070309
APA StyleBibi, Z., Ali, M., Abohashrh, M., Ahmad, I., Khan, H., Ali, M., Akbar, F., Ahmad, N., Iqbal, A., Ullah, F., Ullah, Z., & Muhmood, T. (2023). Biologically Synthesized Silver Nanoparticles Efficiently Control Plant Pathogenic Bacteria-Erwinia carotovora and Ralstonia solanacearum. Inorganics, 11(7), 309. https://doi.org/10.3390/inorganics11070309

